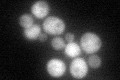
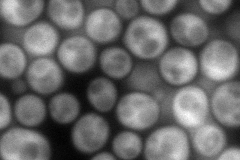
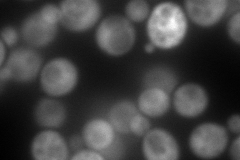
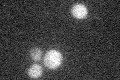

View description
Ribose-5-phosphate ketol-isomerase, catalyzes the interconversion of ribose 5-phosphate and ribulose 5-phosphate in the pentose phosphate pathway; participates in pyridoxine biosynthesis
Localization:
Intensity:
Fold change:
Significance:
-
C’ GFP library in SD
cytosol51.05 -
N' NOP1pr-GFP in SD
cytosol174.213 -
N' TEF2pr-mCherry in SD
cytosol278.421 -
N' NATIVEpr-GFP in SD

cytosol57.6349 -
N' TEF2pr-VC and Cyto-VN in SD

cytosol78.3992 -
C’ GFP library in SD+DTT

cytosol36.060.7No -
C’ GFP library in SD+H2O2

cytosol53.441.04No -
C’ GFP library in Starvation Media
cytosol23.150.45No -
C’ GFP library on the background of Pup2-DaMP

cytosol -
C’ GFP library on the background of CCT mutant

cytosol49.13030.962237No
